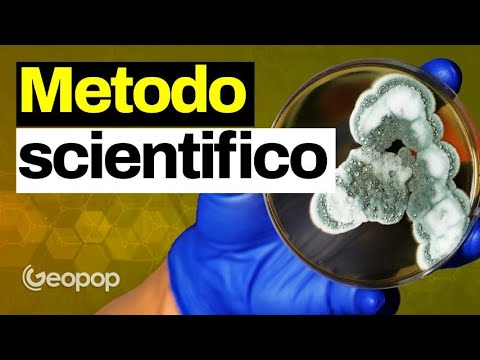
Da errore a scoperta: il percorso della ricerca 🔬

Da errore a scoperta: il percorso della ricerca 🔬
Scopri come un piccolo errore può portare a grandi invenzioni, come il forno, attraverso il processo di ricerca scientifica con @Metamostri.

Geopop
88.3K views • Mar 10, 2025
About this video
Immaginate di andare a lavoro con una barretta di cioccolato in tasca e trovarvi con un’invenzione rivoluzionaria! È successo davvero, e così è nato il forno a microonde! Ma come nascono le grandi scoperte scientifiche? E perché la ricerca è così importante?
In questo video, insieme ai nostri amici dei @Metamostri , vi raccontiamo come funziona il metodo scientifico e perché la ricerca può cambiare la vita di tante persone, proprio come il piccolo Edo, un bimbo che ci ha raccontato la sua storia speciale.
00:00 Quando gli errori portano a grandi scoperte: cos’è il metodo scientifico
01:02 Spiegare la ricerca scientifica ai bambini con un ospite speciale
03:57 La scoperta dei batteri di Fleming: un errore che ha cambiato la storia
04:43 Come funziona il metodo scientifico: le sue fasi spiegate
07:06 La storia di Edo: una malattia rara e la speranza della scienza
10:01 Come scienza e ricerca salvano vite ogni giorno
I NOSTRI VIDEO CONSIGLIATI:
https://www.youtube.com/watch?v=-h0agiD1BAQ
https://www.youtube.com/watch?v=INkjc77Kg4g
#geopop #scienza #metamostri
Credists:
Science Museum London Science and Society Picture Library
Dr. David Midgley
Brandon Seah
Archives nationales (France)
Skilton R_ Cutcliffe L_ Barlow D_ Wang Y_ Salim O_ Lambden P_ Clarke I
Loafer
In questo video, insieme ai nostri amici dei @Metamostri , vi raccontiamo come funziona il metodo scientifico e perché la ricerca può cambiare la vita di tante persone, proprio come il piccolo Edo, un bimbo che ci ha raccontato la sua storia speciale.
00:00 Quando gli errori portano a grandi scoperte: cos’è il metodo scientifico
01:02 Spiegare la ricerca scientifica ai bambini con un ospite speciale
03:57 La scoperta dei batteri di Fleming: un errore che ha cambiato la storia
04:43 Come funziona il metodo scientifico: le sue fasi spiegate
07:06 La storia di Edo: una malattia rara e la speranza della scienza
10:01 Come scienza e ricerca salvano vite ogni giorno
I NOSTRI VIDEO CONSIGLIATI:
https://www.youtube.com/watch?v=-h0agiD1BAQ
https://www.youtube.com/watch?v=INkjc77Kg4g
#geopop #scienza #metamostri
Credists:
Science Museum London Science and Society Picture Library
Dr. David Midgley
Brandon Seah
Archives nationales (France)
Skilton R_ Cutcliffe L_ Barlow D_ Wang Y_ Salim O_ Lambden P_ Clarke I
Loafer
Tags and Topics
Browse our collection to discover more content in these categories.
Video Information
Views
88.3K
Likes
5.3K
Duration
11:33
Published
Mar 10, 2025
User Reviews
4.7
(17) Related Trending Topics
LIVE TRENDSRelated trending topics. Click any trend to explore more videos.
Trending Now